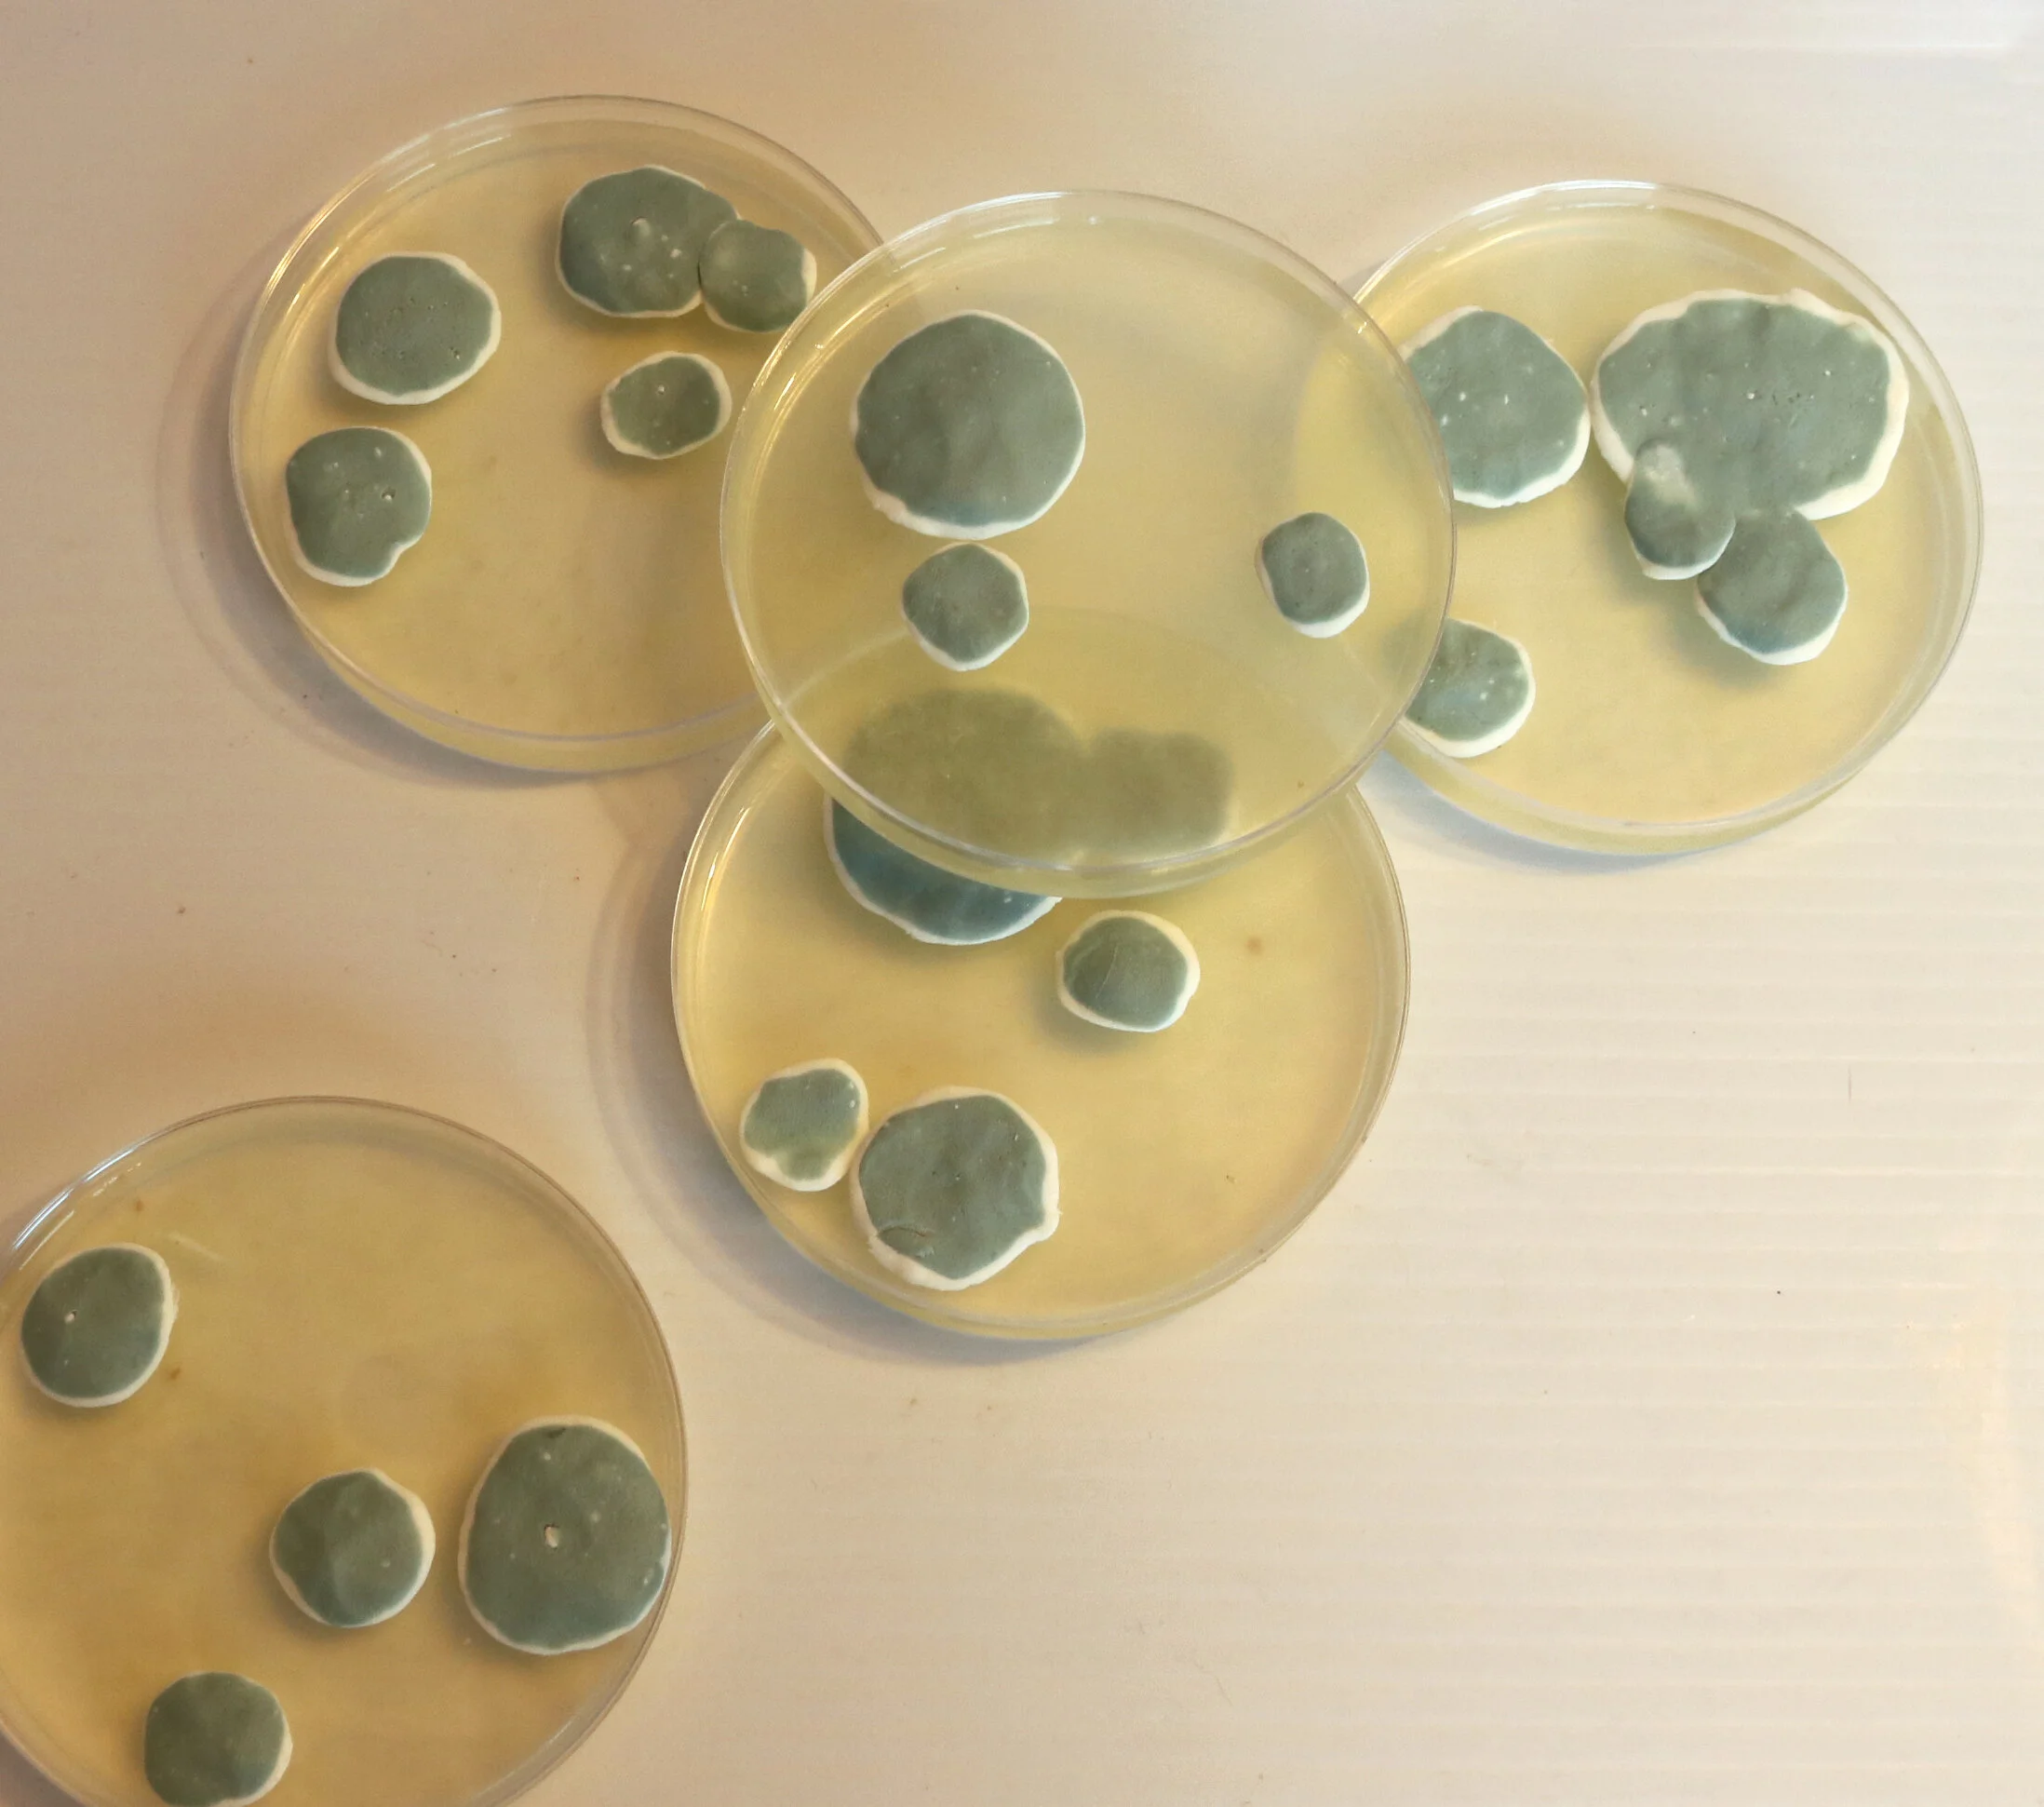

We had a twenties themed NYE party, and as regular readers will know the first round of our quiz IS the buffet table. This year we went for “things that started in the twenties” in silly food form. 30 things/people/places that were invented, born or made in the twenties. Can you name them all??
Got it? Answers as follows……
Sausages: Lady Chatterley’s Lover (published 1928)
Fishfingers: Birdseye Company (founded 1923) or Captain Birdseye (Born 1922)
Chicken drumsticks: The London night bus service (began 1920)
Vol au vent hats containing coronation chicken: The Queen (born 1926)
Houseful of nuts: My house! (built 1925)
Breadsticks: Electricity Pylons (Invented 1928)
“Spinach” - actually Edamame dip: Popeye (character first appeared 1929)
Houmous, with French Foreign Legion soldiers and a family jewel: Beau Geste (published 1924)
Cracker installation: the Chrysler Building (building started 1928)
Cheese board: Mount Rushmore (started 1927)
Tube of Pringles: Dot Cotton, or June Brown (born 1927)
Monster Munch in a bowl: Cthulu (created 1928)
Bailey’s Fudge in the shape of the Giant’s Causeway, with the Derry Girls, George Best and DCI Hastings: Norther Ireland (Established 1921)
Gingerbread: Battersea Power Station (Building started 1929)
Pyramid full of “wonderful things”, quality street rather than gold though: Tutenkhamun’s Tomb (discovered 1923)
Honey/hunny pot containing honeycomb: Winnie the pooh (created 1926)
Jelly with chocolate mould: Penecillin (discovered 1928)
Flying Saucer installation: Buck Rogers (created 1928)
Chocolate footballs: France beat England for the first time at football! (listed on one webpage as happening in the 20s, but actually happened in the 30s, but as we had one french family coming I thought it would'n’t matter!)
Terry’s chocolate orange: The BBC (Formed 1922)
Macarons: The Valentine’s Day massacre (1929)
Jaffa Cakes: Jaffa cakes! (Invented 1927)
Chocolate Money: Wall Street Crash (1929)
Marshmallows: Winter Olympics (started 1924)
Popcorn: Television (Invented 1925)
Peanut butter squares and meringue cacti: Route 66 (built 1926)
Coke cans: Santa Claus…The coco cola company started christmas advertising in the late 20s, including father christmas, although admittedly he wasn’t fat and jolly till the early 30s.
Apple juice: Channel No 5 (released 1921)
Napkins: USSR (Formed 1922)
Paper plates: Mickey Mouse (first appears as Steam Boat Willie in 1928)
That’s it! Beau Geste caused the most difficulties. Did you get all 30?